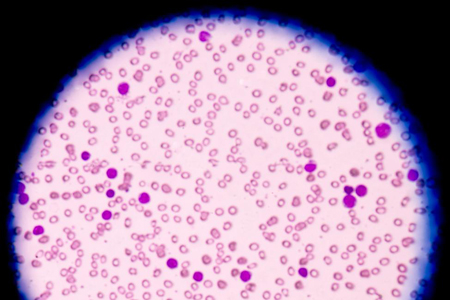

The metabolic approach to cancer treatment (1)
By Dr. Joseph Mercola
Dr. Nasha Winters is a naturopathic physician who specializes in supporting patients with cancer. She also trains clinicians and consults with those treating cancer patients.

• Winters requires five specific tests before she will conduct an initial consultation with a patient. They’re markers to assess the health of the whole body and whether cancer is progressing, stable or regressing
• The first is a blood chemistry panel, an inexpensive blood test showing complete blood count (CBC). Importantly, it shows your neutrophil-to-lymphocyte ratio (NLR), which is prognostic for overall survival. A chem panel (CMP) is also required, which assesses organ function and electrolyte status
• The lactase dehydrogenase (LDH) test is a widely underutilized yet most important test as it is a marker of metabolic function. If LDH is elevated, your mitochondria are functioning poorly
• When high-sensitivity C-reactive protein, LDH and erythrocyte sedimentation rate measurements are within functional ranges, the patient has a good handle on their disease and prognosis is good
Cancer kills an estimated 1,600 Americans each day. In China, 8,100 people a day succumb to the disease. It’s so common, it’s a rare individual who does not know someone who has been diagnosed with cancer – which is why the topic of this interview is so important.
Dr. Nasha Winters is a naturopathic physician who specializes in cancer treatment. While she has treated cancer patients in the past, she’s developed a more efficient model where she now focuses on training clinicians and consulting with those treating patients.
I’ve been very impressed with her work. She has embraced the ketogenic diet and integrates it as a strategic tool in the therapeutic planning. She also uses many other, less well-known strategies. If you’re affected by cancer and believe her skills may be helpful, you can have your clinician consult with her to fine-tune your treatment.
I believe if you catch the cancer early enough, most are likely curable. But you need to catch it early, and you need to have the proper know-how. It’s also important to avoid strategies that are going to set you back.
“My life’s goal is to eventually be able to … make a tiny little dent in that statistic,” Winters says. “Where we can be effective is with the folks who … are in a position where they’re still well enough and motivated enough to explore beyond their standard of care options, because that’s often not enough, frankly, in today’s time. And then also, I think the biggest impact that we can have … is we can help people look under the hood long before it’s a problem. Because really, the only true cure is prevention. We’ve got sort of layers of this.
We’ve got the folks who don’t yet have cancer or don’t yet know they have it. We have the folks who are already diagnosed or in a relatively good state of health, whether it’s a Stage 1 to a Stage 4. Then we have some of the folks who are really damaged from years of unsuccessful treatments that have left their bodies broken and maybe not as responsive to this approach.”
The facts speak for themselves
Almost without exception, people will say they thought they were healthy up until they received their cancer diagnosis. However, that’s simply impossible. Cancer, like many other diseases, does not manifest until you’re about 80% of the way down the proverbial hole.
The first symptom is not the cancer diagnosis itself. Most cancers take years to progress to the point of being diagnosable. Cancer is a res ipsa loquitur factor, meaning “the facts speak for themselves.” In other words, you, in some way, shape or form, were not leading a healthy lifestyle – or you simply failed to counteract the inevitable toxic exposures we’re all subject to in today’s modern world. As noted by Winter:
“No matter how much you try, we are being exposed to many things that we don’t see, that we are not aware of, that are definitely damaging our container in a way that our cells are having a harder and more difficult time … to respond and repair the way they should.
That’s one of the strategies I’m helping physicians understand. Because our medical system is not geared towards prevention … We’re very much waiting for a house to be engulfed in flames before we decide to spit a little bit of water on it, right? My strategy has always been ‘Test, assess, address and then adjust accordingly and repeat as often as needed.’”
Test, assess and address – The complete blood count test
Winters recommends, and in fact requires, five specific tests before she will conduct an initial consultation with a patient. They’re markers of how advanced the cancer is and how well you’re doing as you’re progressing through treatment.
The first is a blood chemistry panel. This is a simple and inexpensive blood test showing complete blood count (CBC) with differential. That includes things like your white blood cells, red blood cells, hemoglobin, hematocrit and platelets.
Most importantly, it shows your neutrophil-to-lymphocyte ratio (NLR), which is prognostic for overall survival. One of the reasons why immunotherapies are seeing such a low response rate – only about 20%, according to Winters – is because of this neutrophil-to-lymphocyte ratio.
As explained by Winters, when your neutrophils are too elevated and your lymphocytes too low, you do not have a normally functioning immune system. As a result, treatment with some of these new, innovative immune therapies used in oncology may “tilt the teeter-totter of your immune system into a dangerous place of overreactivity,” she says, adding “For a $12, paid-out-of-your-pocket, walk-in lab test, you get a really good sense of where your immune system lies.”
Overall, you want a 2-to-1 ratio or better of the neutrophil cells to the lymphocytes. If you go much higher than that, that bigger divide between neutrophils and lymphocytes becomes problematic. Conversely, if you have a “switched NLR,” where the lymphocytes are more elevated than the neutrophils, that’s often a symptom of blood dyscrasias and blood cancers “that are not uncommon after standard of care therapy,” Winters says.
Additionally, you want your white blood cell count to be between 5 and 7. Anything lower than that, which is common in conventional therapy, makes the situation more challenging. Platelets elevated above 250 is also prognostic. The sweet spot for platelets is between 175 and 250. Below 175, immune function and blood clotting are compromised; the same is true for levels above 250.
“Oftentimes elevated platelets can be a good example of a cancerous process. In fact, that’s one of the alarms that we’ll see in early-stage cancers,” Winters says. Elevated platelets are also related to viral patterns, and may be indicative of a co-infection causing immune dysregulation.
“The other piece we often forget about is things like the hemoglobin. If the hemoglobin is low and you happen to be someone who’s monitoring your ketones or your blood counts, your hemoglobin A1C, you’re going to get some erroneous numbers because you have to have enough hemoglobin to actually get a true result.
They are simple little tricks that we can use with a basic CBC just to see how somebody’s immune system is during treatment, after treatment and prior to treatment. It’s worth running on your own and paying cash for it just to look under the hood.”
Sadly, most oncologists have never even heard about the NLR ratio or the fact that platelets are a prognostic factor for progression of disease or even early warning signs of cancer, Winters says. In the world of conventional oncology, the CBC is primarily used to make sure the white blood cell count and neutrophils are high enough for you to be able to receive another dose of chemo or targeted therapy.
The comprehensive metabolic panel and lactase dehydrogenase
The second test Winters routinely recommends is a comprehensive metabolic panel (CMP), sometimes known as the chem panel, which is another inexpensive test. This test will provide you with information about your electrolytes, organ functions and cardiovascular function, as well as kidney and liver function.
“This is also a super important clue to see what’s going on,” she says. “For instance, if your creatinine is moving above 1, we know that your kidneys are struggling. They’re not filtering properly. Or if your liver enzymes are starting to move above 20 or 25, we know there are some issues around how your liver is processing things along the way.
If alkaline phosphatase is raising, that can often show us first signs of bone loss or bone metastasis. These are some really powerful ways to assess people’s response to the medications, because those enzymes will often go up when they’re being beaten up by some drugs. But it’s also a really good way to get a sense that there are other organs involved in the overall cancer process.”
In the past, the chem-20 and chem-24 tests included two important tests that must now be ordered separately. One of them is the lactase dehydrogenase (LDH) test, “which is probably the most underutilized and most important test across all chronic illness patterns,” Winters says. It is a marker of metabolic function. If LDH is elevated, your mitochondria are functioning poorly.
“You can even break down that overall LDH into its five constituents of these five isoenzymes and really know precisely where the hiccups are happening in that metabolic process, whether it’s at the level of the bone, the lung, the kidney, the liver, the red blood cell. Pretty fascinating, and again, very inexpensive,” she says.
“This is also the main way to monitor things like lymphoma, most leukemias, multiple myeloma and even melanoma. It is considered sort of the cancer marker for those. Yet it’s a very misused and even misunderstood and forgotten lab test. I can’t tell you how many times I’ve asked doctors to run an LDH for the patient and I’ll get back a low-density lipoprotein (LDL). It would happen 2 out of 10 times.”
What LDH can tell you about your mitochondrial function

So, what exactly is the connection between LDH and mitochondrial function?
Winters explains:
“This is where we’re looking at how we are processing lactase dehydrogenase – the process of how we’re fermenting or processing our energy through our Krebs cycle … to produce adenosine triphosphate (ATP). It’s intimately in relationship to the dehydrogenases, whether it’s pyruvate or lactate dehydrogenase.
This starts to give you some clues that all is not well in the mitochondrial building when that level starts to rise. Interestingly enough, one thing I neglected to mention as we started talking about the labs is that labs, of course today, are based on the average of the population in the region in which they’re being run. For instance, if you live in Alabama and you’re running a glucose level, they’re still saying you’re fine in 120 fasting glucose.
If you’re in Colorado, they’re saying that 90 is fine. It even varies from region to region. But overall, you don’t want to be average today with regards to your lab values. When I’m talking about my functional ranges or ideal ranges – for instance, the lactase dehydrogenase through, say, LabCorp – it should be ideally under 175.
I believe the cutoff is around 263. If you run it through Quest, that’s a different metric that they run and should not be under 450. It has a higher cutoff at around 600 or 650. You want to be well under the top end on lactase dehydrogenase for optimal ranges.
When you’re too low, that’s often a major indicator of extreme malnutrition, often muscle breakdown, muscle wasting, sarcopenia, cachexia, which is also a very dangerous place to be in the pendulum of an oncology or chronic illness process.”
The Erythrocyte sedimentation rate test
The second test that used to come standard with the chem panel, but no longer is included, is your sedimentation rates, also known as the erythrocyte sedimentation rate (ESR). “This is a really powerful simple test that just looks at how fast your cells are falling out of solution, falling out of the plasma,” Winters says.
Ideally, you’ll want an ESR rate below 10. Above 10, it suggests it’s more difficult for your cells to exit the thick, fibrinolytic, sticky webbing or scaffolding associated with chronic inflammation, autoimmunity and increased risk of metastasis.
“You don’t typically die from primary cancers unless they’re strategically placed in some valuable real estate in the body,” she says. “However, we do have a higher incidence of death from metastasis. When I look at that [ESR] number, it tells me how smoothly things are flowing through the system of the body.”
The high-sensitivity C-reactive protein test
The fifth test Winters routinely recommends is the high-sensitivity C-reactive protein (hsCRP) test. While this test is typically used as an indicator of cardiovascular health, it’s also a widely underutilized prognostic factor for cancer. Elevated CRP, no matter what kind of disease or condition you have, suggests a poor prognosis and lower survival rate.
CRP differs from ESR in that it is a general marker of inflammation. It doesn’t show you the location of the inflammation. Ideally, you want a CRP below 1. If the lab uses a cutoff of 0.3, you’ll want a value below 0.1. Be sure to get a quantitative hsCRP – i.e., one that specifies your level and not just tells you whether you’re in, under or above range – as this will allow you to monitor your progress more closely.
Common cancer pattern

“Here’s where the interesting pieces come together,” Winters says. While all of those five tests, individually, have good studies backing their role in monitoring the cancer process and other inflammatory processes, what Winters has learned, through 25 years of looking at them, is that when CRP, LDH and ESR are within functional ranges, she knows the patient has a good handle on their disease. When all three are off, the prognosis weakens. Again, the functional or ideal ranges would be:
• ESR below 10
• CRP below 1 (or 0.1 depending on the measurement used)
• LDH below 175 (or 450 depending on the measurement used)
“No matter what the scan, no matter what the tumor markers tell me, I know that patient’s terrain and mitochondrial metabolic health is still robust enough that no matter what the tumor burden, we can still move this vehicle down the road,” she says.
“If I see for instance a thrown-off ESR [alone], I know they’re likely having some type of autoimmune response. We see this a lot in rheumatoid arthritis (RA), Sjogren’s [and] Hashimoto’s flares.
Or if we have, let’s say, a CRP that’s really out of range but the other two are perfect, that could be that you just had dental work or had a really intense workout or stubbed their toe or stepped on their child’s Lego.
The LDH might be that they had a bender, drinking with their friends for the weekend, or have been taking some steroids and their bones are breaking down very quickly, or just went and did a humongous hike and broke down some muscle very, very quickly.
But collectively? That’s the key. When all three are in the functional range, the body is still in control. When [all three] start to rise, that’s when we know we’re on a slippery slope … That basically means the cancer stem cells are lining up to take action. That’s what we don’t have very good success with in Western medical treatment strategies.”
Read the second part of the article
yogaesoteric
October 6, 2019
Also available in:

